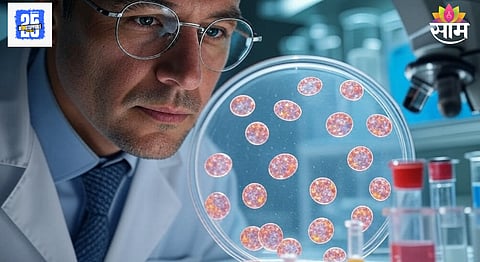
Cancer cells after radiotherapy

कॅन्सरवर वेळीच उपचार घेतले तर या आजारापासून मुक्तता होऊ शकतो. अनेकदा शस्त्रक्रिया केल्यानंतर रूग्णाला रेडिएशन थेरेपी किंवा किमोथेरेपी दिली जाते. कॅन्सरच्या रुग्णांसाठी रेडिओथेरपी हा एक प्रभावी उपचार मानला जातो. मात्र नुकत्यात झालेल्या एका संशोधनातून धक्कादायक गोष्ट समोर आली आहे. शास्त्रज्ञांनी इशारा दिला आहे की, रेडिओथेरपीनंतरही लहान कॅन्सरच्या पेशी शरीरात राहू शकतात, ज्या स्कॅनमध्ये दिसत नाहीत.
तज्ज्ञांच्या म्हणण्यानुसार, या पेशी भविष्यात पुन्हा कॅन्सर होण्याची शक्यता वाढवतात. यामुळे रुग्णाच्या जीवाला गंभीर धोका निर्माण होऊ शकतो. शिकागो विद्यापीठाच्या मेडिकल सेंटरमधील संशोधकांनी हे उघड केलं आहे.
संशोधनानुसार, रेडिओथेरपीनंतर केलेल्या स्कॅनमध्ये अनेकदा असं दिसून आलंय की, ट्यूमर पूर्णपणे नाहीसा झालेला नसतो. परंतु जेव्हा काही महिन्यांनंतर किंवा वर्षांनी बायोप्सी केली जाते तेव्हा स्कॅनद्वारे आढळून न आलेल्या उर्वरित कॅन्सरच्या पेशी पुन्हा आढळून येतात.
तज्ज्ञांच्या मतानुसार, यावेळी केवळ स्कॅनच्या निकालांवर अवलंबून राहू नये. अशामध्ये उपचारानंतर, कॅन्सरच्या पुनरावृत्तीचा धोका कमी करण्यासाठी रुग्णाच्या स्थितीचं बारकाईने निरीक्षण करणं आणि अतिरिक्त चाचण्या करणं खूप महत्वाचं आहे.
संशोधकांच्या मते, फुफ्फुस, यकृत, प्रोस्टेट आणि इतर अवयवांच्या कॅन्सरवर उपचार करण्यासाठी स्टिरिओटॅक्टिक अॅब्लेटिव्ह रेडिओथेरपी (SABR) नावाची एक विशेष रेडिओथेरपी तंत्र वापरलं जातं. हे तंत्र अतिशय अचूकपणे रेडिएशन देतं आणि स्कॅनमध्ये चांगले परिणाम दाखवत असल्याचं समोर आलं आहे. मात्र पूर्णपणे स्कॅनवर अवलंबून राहणं धोकादायक ठरू शकतं.
फुफ्फुसांच्या कॅन्सरच्या ४०% प्रकरणांमध्ये, किडनी कॅन्सरच्या ५७-६९% प्रकरणांमध्ये, प्रोस्टेट कॅन्सरच्या ७.७-४७.६% प्रकरणांमध्ये उपचारांनंतर काही काळाने बायोप्सी केल्यानंतर तपासणीत कॅन्सरच्या पेशी आढळल्या. दरम्यान यावेळी स्कॅनमध्ये काहीही दिसून आलं नाही.
संशोधकांच्या म्हणण्यानुसार, ज्यावेळी लहान कॅन्सरच्या पेशी शरीरात राहतात तेव्हा भविष्यात कॅन्सरचा पुन्हा होण्याचा धोका वाढतो. कॅन्सर हा केवळ एखाद्या अवयवापुरता मर्यादित नाही तर तो शरीराच्या इतर भागांमध्येही पसरू शकतो. त्यामुळे उपचारांनंतर पूर्णपणे काळजी घेणं आणि तज्ज्ञांनी सांगितलेल्या इतर टेस्ट करणंही महत्त्वाचं आहे.
सकाळ+चे सदस्य व्हा
शॉपिंगसाठी 'सकाळ प्राईम डील्स'च्या भन्नाट ऑफर्स पाहण्यासाठी क्लिक करा.
Read Marathi news and watch Live TV. Breaking news from Maharashtra, India, Pune, Mumbai, Politics, Entertainment, Sports, Lifestyle at SaamTV. Get Live Marathi news on Mobile. Download the Saam Tv app for Android and IOS.